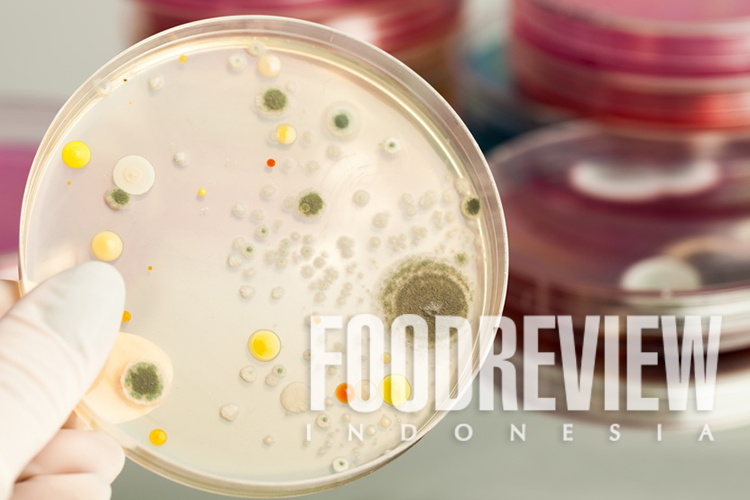

Dari sejak dilahirkan, manusia telah diberikan banyak keberuntungan. Salah satunya adalah beneficial microbes (BM) yang diperoleh. Bakteri-bakteri ini memberikan peran yang luar biasa. Membantu bayi dalam mencerna makanan pertamanya (ASI), melindungi dari mikroorganisme penyebab penyakit (patogen), dan menjadi salah satu faktor penentu perkembangan positif aspek biologis dan psikisnya. BM didapatkan pada saat proses persalinan normal oleh seorang ibu.
Selain makanan dan minuman, interaksinya dengan tanaman, hewan, tanah, dan berbagai tanaman, hewan, dan tanah yang pada akhirnya akan memperkaya ragam BM yang dimiliki oleh seorang anak manusia. Seluruh mikroorganisme tersebut kemudian menjadi bagian tak terpisahkan dari fungsi tubuh manusia dan disebut sebagai mikrobiom manusia.
Lebih lengkapnya silakan baca di Foodreview Indonesia edisi Desember 2020: Sustainable Snacks. Pembelian & Berlangganan hubungi kami: langganan@foodreview.co.id/(0251) 8372-333/WhatsApp: 0811-1190-039.
Newsletter: http://bit.ly/fricommunity
Search FOODREVIEW on TOKOPEDIA & SHOPEE
#foodreviewindonesia #foodscience #foodtechnology #ilmupangan #teknologipangan #industripangan #sustainable #snacks

